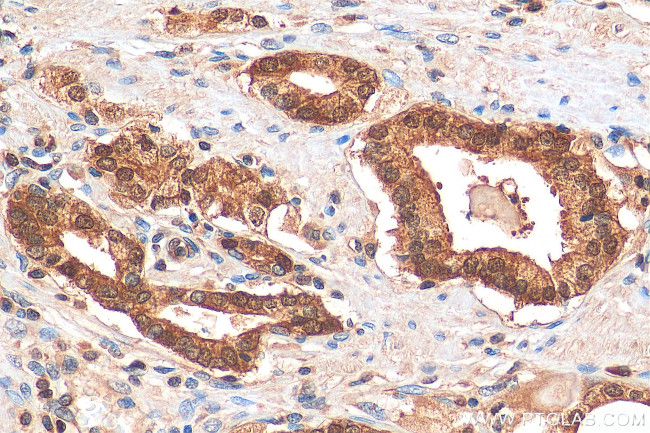
HDDC3 Antibody in Immunohistochemistry (Paraffin) (IHC (P))
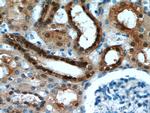
HDDC3 Antibody in Immunohistochemistry (Paraffin) (IHC (P))

Search
Proteintech
HDDC3 Polyclonal Antibody
{{$productOrderCtrl.translations['antibody.pdp.commerceCard.promotion.promotions']}}
{{$productOrderCtrl.translations['antibody.pdp.commerceCard.promotion.viewpromo']}}
{{$productOrderCtrl.translations['antibody.pdp.commerceCard.promotion.promocode']}}: {{promo.promoCode}} {{promo.promoTitle}} {{promo.promoDescription}}. {{$productOrderCtrl.translations['antibody.pdp.commerceCard.promotion.learnmore']}}
产品信息
21091-1-AP
种属反应
宿主/亚型
分类
类型
抗原
偶联物
形式
浓度
规格
纯化类型
保存液
内含物
保存条件
运输条件
产品详细信息
Immunogen sequence: MGSEAAQLL EAADFAARKH RQQRRKDPEG TPYINHPIGV ARILTHEAGI TDIVVLQAAL LHDTVEDTDT TLDEVELHFG AQVRRLVEEV TDDKTLPKLE RKRLQVEQAP HSSPGAKLVK LADKLYNLRD LNRCTPEVKI Q (1-140 aa encoded by BC033794)
靶标信息
HDDC3 is involved in biological processes as a hydrolyzing enzyme in starvation response.
仅用于科研。不用于诊断过程。未经明确授权不得转售。
生物信息学
蛋白别名: (ppGpp)ase; Guanosine-3',5'-bis(diphosphate) 3'-pyrophosphohydrolase MESH1; HD domain-containing protein 3; MESH1; Metazoan SpoT homolog 1; metazoan SpoT homolog-1; myeloid leukemia noncoding regulatory locus on chromosome 15; Penta-phosphate guanosine-3'-pyrophosphohydrolase
基因别名: (ppGpp)ase; 1110033O09Rik; C86475; HDDC3; MESH1; MYNRL15; RGD1311839
UniProt ID: (Human) Q8N4P3, (Mouse) Q9D114
Entrez Gene ID: (Human) 374659, (Rat) 308758, (Mouse) 68695